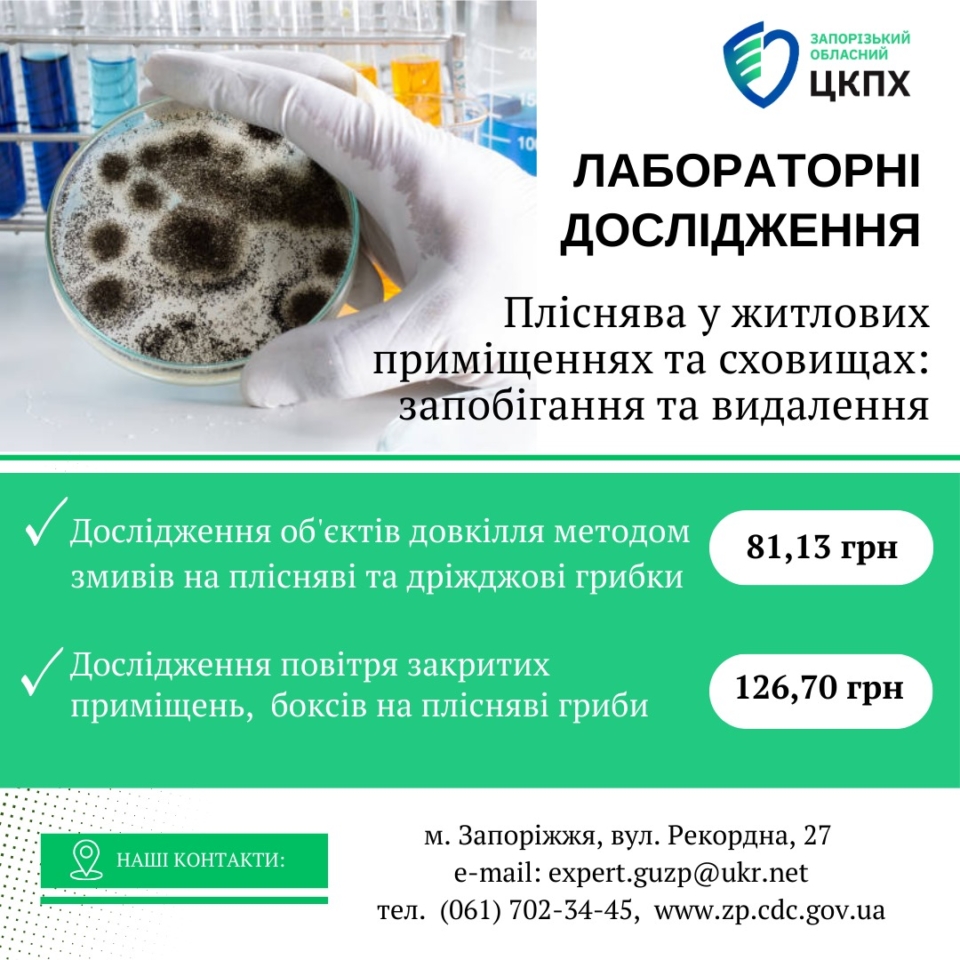

Пліснява у житлових приміщеннях та сховищах: запобігання та видалення
1 травня 2025
#лабораторні_дослідження
Пліснява – це збірна назва для великої кількості видів мікроскопічних грибів, які можуть рости у приміщеннях, де є волога. Пліснява може мати різний колір, включаючи чорний, білий, зелений, коричневий та інші. Найчастіше зустрічаються Aspergillus, Penicillium, Cladosporium та Stachybotrys chartarum (чорна пліснява).
Чому пліснява небезпечна?
Пліснява виділяє спори, які можуть викликати ряд проблем зі здоров’ям, зокрема:
• Алергічні реакції: чхання, свербіж, нежить, почервоніння очей.
• Респіраторні проблеми: кашель, хрипи, задишка, загострення астми.
• Подразнення шкіри та слизових оболонок.
• У людей з ослабленим імунітетом або хронічними захворюваннями пліснява може спричинити серйозніші інфекції легень.
Особливу небезпеку становить чорна пліснява (Stachybotrys chartarum), яка може виробляти мікотоксини, що є токсичними для людини.
Де найчастіше росте пліснява?
Пліснява процвітає у вологих місцях з поганою вентиляцією. Ось найпоширеніші місця її зростання:
• Ванні кімнати: через високу вологість від душу та ванни.
• Підвали та льохи: через проникнення вологи з ґрунту та погану вентиляцію.
• Кухні: особливо навколо раковин та місць протікання води.
• Місця протікання даху або труб: будь-які місця, де є неконтрольоване надходження води.
• Сховища та комори: особливо якщо вони недостатньо провітрюються.
💡 Як запобігти появі плісняви?
Запобігання – найкращий спосіб боротьби з пліснявою. Ось декілька ключових порад:
1. Контроль вологості:
– використовуйте вентилятори у ванних кімнатах та на кухні;
– застосовуйте осушувачі повітря у вологих приміщеннях, таких як підвали;
– підтримуйте рівень вологості в приміщенні на рівні 30-50%.
2. Забезпечення вентиляції:
– регулярно провітрюйте приміщення, відкриваючи вікна;
– переконайтеся, що вентиляційні системи працюють належним чином;
3. Усунення протікань:
– негайно ремонтуйте будь-які протікання даху, труб чи кранів.
– слідкуйте за конденсацією на вікнах та трубах і вживайте заходів для її зменшення.
4. Регулярне прибирання:
– регулярно очищайте поверхні, щоб запобігти накопиченню пилу та бруду, на яких може рости пліснява.
– використовуйте засоби для чищення, які запобігають росту плісняви.
Як видалити плісняву, якщо вона вже з’явилася?
Якщо ви виявили плісняву, важливо її негайно видалити, щоб запобігти подальшому поширенню та проблемам зі здоров’ям.
1. Захистіть себе:
– Одягніть рукавички, маску (бажано респіратор) та захисні окуляри, щоб уникнути контакту зі спорами плісняви.
2. Ізолюйте уражену ділянку:
– Якщо можливо, закрийте двері та вікна в кімнаті, щоб запобігти поширенню спор в інші приміщення.
3. Видаліть уражені матеріали:
– Матеріали, які сильно пошкоджені пліснявою і не підлягають очищенню (наприклад, гіпсокартон, килими, ізоляція), слід обережно видалити та викинути.
4. Очистіть поверхні:
– Для твердих поверхонь використовуйте жорстку щітку та розчин мила та води.
– Для дезінфекції можна використовувати розчин відбілювача (1 частина відбілювача на 10 частин води), але ніколи не змішуйте відбілювач з аміаком або іншими миючими засобами, оскільки це може утворити токсичні пари.
– Ретельно висушіть всі поверхні після очищення.
5. Очищення м’яких матеріалів:
– Килими, оббивку та інші м’які матеріали можна спробувати очистити за допомогою пилососа з -фільтром або професійних засобів для чищення килимів.
– У деяких випадках може знадобитися викинути сильно уражені м’які матеріали.
6. Запобігання повторному росту:
– Після очищення важливо вжити заходів для запобігання повторному росту плісняви, дотримуючись порад, наведених вище (контроль вологості, вентиляція тощо).
Лабораторні дослідження на наявність плісняви у житлових приміщеннях та сховищах можна зробити за доступними цінами на базі Лабораторного центру ДУ «Запорізький ОЦКПХ МОЗ».
Запрошуємо звертатися за контактами: (061) 702-34-45, е-mail: [email protected]


